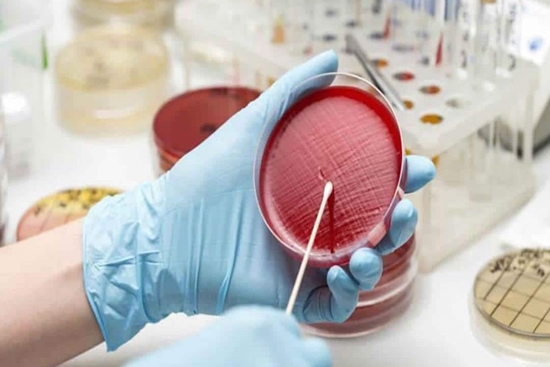

توسط محققان دانشگاه انجام شد
نمونه برداری از تعدادی ترکیبات اتری سوخت در نمونههای ادرار
محققان دانشگاه علوم پزشکی شهید بهشتی موفق به نمونهبرداری از تعدادی ترکیبات اتری سوخت در نمونههای ادرار شدند که آنالیز آنها در نمونههای بیولوژیک معمولاً کار بسیار سختی است.
به گزارش روابط عمومی دانشگاه علوم پزشکی شهید بهشتی و به نقل از دانشکده بهداشت و ایمنی، طرح تحقیقاتی «توسعه نمونه بردار تله سوزنی بر پایه فضای فوقانی به منظور نمونه برداری از تعدادی ترکیبات اتری سوخت در نمونه های ادرار» با راهنمایی دکتر رضوان زندهدل مجری اصلی طرح و توسط وحید جلیلی انجام شد.
وحید جلیلی درباره اهداف و دستاوردهای این پروژه توضیح داد: امروزه مسئله مصرف سوخت های فسیلی و بنزینی نگرانیهایی را برای تمامی اقشار جامعه به وجود آورده است. برای این منظور جهت کاهش عوارض ناشی از مصرف این سوخت ها از جمله انتشار گازهای گلخانه ای و گازهای سمی با استفاده از افزودنیهایی تحت عنوان افزودنیهای سوختی که ترکیبات اتری هستند بهبود می بخشند.
وی ادامه داد: این ترکیبات اتری می تواند عدد اکتان بنزین را بالا برده و کارکرد آن را در موتورهای درونسوز بهبود ببخشند. اما انتشار این ترکیبات چه در تهیه مراحل آنها و چه در مراحل حمل و نقل و نهایتاً در مصرف بنزین که همراه با بنزین سوزانده می شود؛ می تواند برای سلامت انسان و محیط زیست آسیبزا باشد.
جلیلی با بیان اینکه سردسته این ترکیبات مادهای با نام متیل ترشیاری بوتیل اتر (MTBE) است که به دلیل مشکلاتی که در ارتباط با سرطانزایی آن مطرح است، امروزه در کشور آمریکا مصرف آن ممنوع شده، یادآور شد: اما همچنان طیف گسترده ای از کشورهای اروپایی و آسیایی از جمله کشور ایران تا حدودی از این ماده استفاده می کنند.
وی افزود: البته جایگزین هایی مطرح شده است مثل ترکیبی با عنوان اتیل ترشیاری بوتیل اتر (ETBE) چون از یک خانواده هستند عوارض سمشناسی آنها هم تقریباً مشابه است. بنابراین نیاز است که این ترکیبات را چه در نمونه های هوا و چه در نمونه های بیولوژیک مثل نمونه ادرار بتوان به خوبی آنالیز کرد.
جلیلی با بیان اینکه آنالیز این ترکیبات در نمونه های بیولوژیک معمولاً کار بسیار سختی است، درباره دلیل این دشواری گفت: ترکیبات زیادی در نمونه های بیولوژیک (خون، ادرار و ...) وجود دارد که اجازه نمی دهند تا ترکیبات هدف را استخراج و آنالیز کرد؛ بنابراین نیازمند روشی هستیم که بتوانیم به صورت انتخابی ترکیبات هدف را آنالیز کنیم.

وی درباره این روش توضیح داد: بدین منظور در این طرح جاذب قالب مولکولی را در سه سطح مختلف طراحی و سنتز شد و مورد مقایسه قرار گرفت. در نهایت جاذب قالب مولکولی را که توانست بهترین کارایی و جذب را برای ترکیبات هدف داشته باشد در روشی تحت عنوان «ابزار تله سوزنی» به عنوان فاز استخراج به کار گرفته شد تا بتوان این ترکیبات را از نمونه های ادرار استخراج کرد.
وحید جلیلی یادآور شد نتایج این مطالعه را مطلوب ارزیابی کرد و گفت: این ترکیبات به صورت انتخابی حتی در حضور ترکیباتی که می توانند مداخله گر این ترکیبات باشند؛ اندازه گیری شد.
به گفته جلیلی سرعت و حساسیت بالا در اندازهگیری و امکان تجزیه و تحلیل همزمان ترکیبات مختلف از جمله دستاوردهای این مطالعه است.
وی انتخاب پذیری بالای آن را حتی در صورت حضور ترکیبات مشابه که میتوانند مشکلساز باشند مزیت ویژه این روش عنوان کرد.
این محقق در ادامه افزود: این محصول برای ذینفعان مختلف از جمله معاونت بهداشتی وزارت بهداشت، کارشناسان بهداشت حرفهای، به خصوص صنایع نفتی شامل پالایشگاه ها، پتروشیمی، پمپ بنزین ها و حتی سیستم های حمل و نقل مواد سوختی میتواند بسیار مفید باشد.
جلیلی در خصوص تجاری سازی محصول توضیح داد: در حال بررسی و انجام اقدامات لازم جهت تجاری سازی این محصول هستیم. همچنین نیازمند آن هستیم که در پژوهشهای آینده این روش هرچه بیشتر در محیط های واقعی و تعداد نمونه های بالاتر خصوصاً در صنایع نفتی و در شرایط مختلف آب و هوایی به کار گرفته شود.
در پایان جلیلی ضمن تشکر و قدردانی از همکاران طرح یادآور شد: با توجه به اینکه برای روش ابزار تلهسوزنی جاذبهای مختلفی در بازار وجود دارد اما هیچکدام اختصاصی عمل نمیکنند؛ امید است با حمایتهای لازم و تلاشهای بیشتر این جاذب های تجاری با جاذب سنتز شده ما مقایسه و کارایی و کاربرد جاذب طراحی شده نمایان شود و بتوان این روش را از آزمایشگاه به صنعت منتقل کرد.

این تحقیق با چاپ مقالهای در مجله معتبر Food Chemistry به پایان رسیده است.
انتهای پیام/
کدخبرنگار: 7703م.ر
